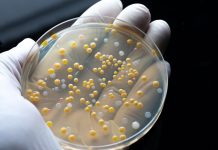
Tackling Europe’s antimicrobial resistance problem with QuantaMatrix’s technologies antimicrobial resistance

Innovation News Network brings you the latest research and innovation news from the fields of science, environment, energy, critical raw materials, technology, and electric vehicles.
AI innovations to power UK’s clean energy future
Innovators from across the country can support the UK’s clean energy future with AI to deliver net zero by 2050.
Global antibiotic usage rises 21% since 2016, increasing AMR
A recent study reveals fluctuating but significant increases in global antibiotic usage, highlighting the urgent need for action against AMR.
Western Space: Interdisciplinary space science to tackle major societal challenges
Western Space's interdisciplinary approach to space science is addressing the key challenges facing today’s world.
Antimicrobial resistance: Should we be worried?
Valerie Edward-Jones provides insights into the AMR landscape and effective strategies to combat this urgent health threat.
Auto Trader, ChargeUK, and SMMT unite to combat electric car misinformation
Auto Trader has partnered with ChargeUK and the Society of Motor Manufacturers and Traders (SMMT) to address electric car misinformation.
The role of sustainable energy in construction
With a few years left to meet global goals and help the environment, the construction industry must step up and adopt sustainable energy.
Tackling Europe’s antimicrobial resistance problem with QuantaMatrix’s technologies
Discover how Quantamatrix has developed innovative technologies to help tackle antimicrobial resistance in Europe.
U701V ULT freezer: A welcome innovation for energy-efficient cold storage in life sciences
Ultra-low temperature (ULT) freezers play a critical role in life sciences, offering the necessary cold storage solutions for delicate biological materials that require strict...
Alberta: A Canadian province of clean energy and opportunity
NAIT Industry Solutions partners with industries to develop clean technologies, protect intellectual property, and maximise research funding.
Quantum chromodynamics at the intensity frontier with a precision microscope
Discover how the Solenoidal Large Intensity Device (SoLID) at Jefferson Lab will revolutionize the study of quantum chromodynamics.